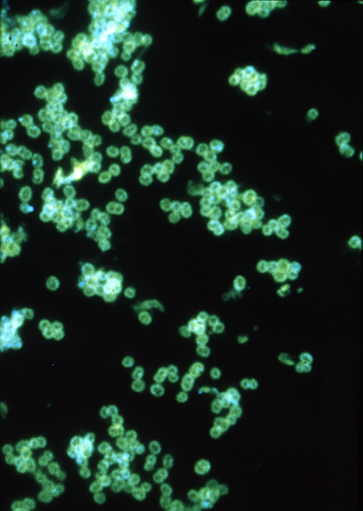

Helicobacter pylori - Tipy a rady pro vaše zdraví
Přečtěte si zajimávé články z oblasti zdraví a krásy, které vám pravidelně přinášíme.
Vše na jednom místěZboží odešleme ještě dnesNakupte z pohodlí domova1. internetová lékárna
Voctářova 2449/5, Praha
Helicobacter pylori
Bakterie
Helicobacter pylori (název složen ze slov: „helix“–šroubovice, „bacter“–bakterie, „pylorus“–vrátník) je druh mikroaerofilní gramnegativní patogenní bakterie, jež napadá sliznici žaludku. Odhaduje se, že je ve vyspělých zemích touto bakterií infikována více než polovina dospělých po 60 letech věku, ačkoliv nemusí vždy vyvolat onemocnění. Způsobuje zejména žaludeční… Wikipedia
Lidé také hledají
Helicobacter pylori – Wikipedie
Helicobacter pylori (název složen ze slov: „helix“–šroubovice, „bacter“–bakterie, „pylorus“–vrátník [1 ]) je druh mikroaerofilní gramnegativní patogenní bakterie, jež napadá sliznici žaludku.
Helicobacter pylori - Wikipedia
Helicobacter pylori, previously known as Campylobacter pylori, is a gram-negative, flagellated, helical bacterium. Mutants can have a rod or curved rod shape that exhibits less virulence. [1 ] [2 ] Its helical body (from which the genus name…
Helicobacter pylori – WikiSkripta
Internetové studijní materiály pro studenty českých a slovenských lékařských fakult.
Soubor:Helicobacter Pylori Urease.png – Wikipedie
PD-Author. (Original text : "The contents of PDB are in the public domain. Online and printed resources are welcome to include PDB data and images from the Structure Explorer pages, as long as they are not for sale as commercial items…
Helicobacter pylori | Příznaky, prevence, jídelníček, dieta -
Co je helicobacter pylori? Helicobacter pylori (H.pylori) je bakterie žijící v žaludku. Příznaky helicobacteru Prevence Jídelníček Dieta
odkazuje na služby nejen od Seznam.cz.
© 1996–2025 Seznam.cz, a.s.